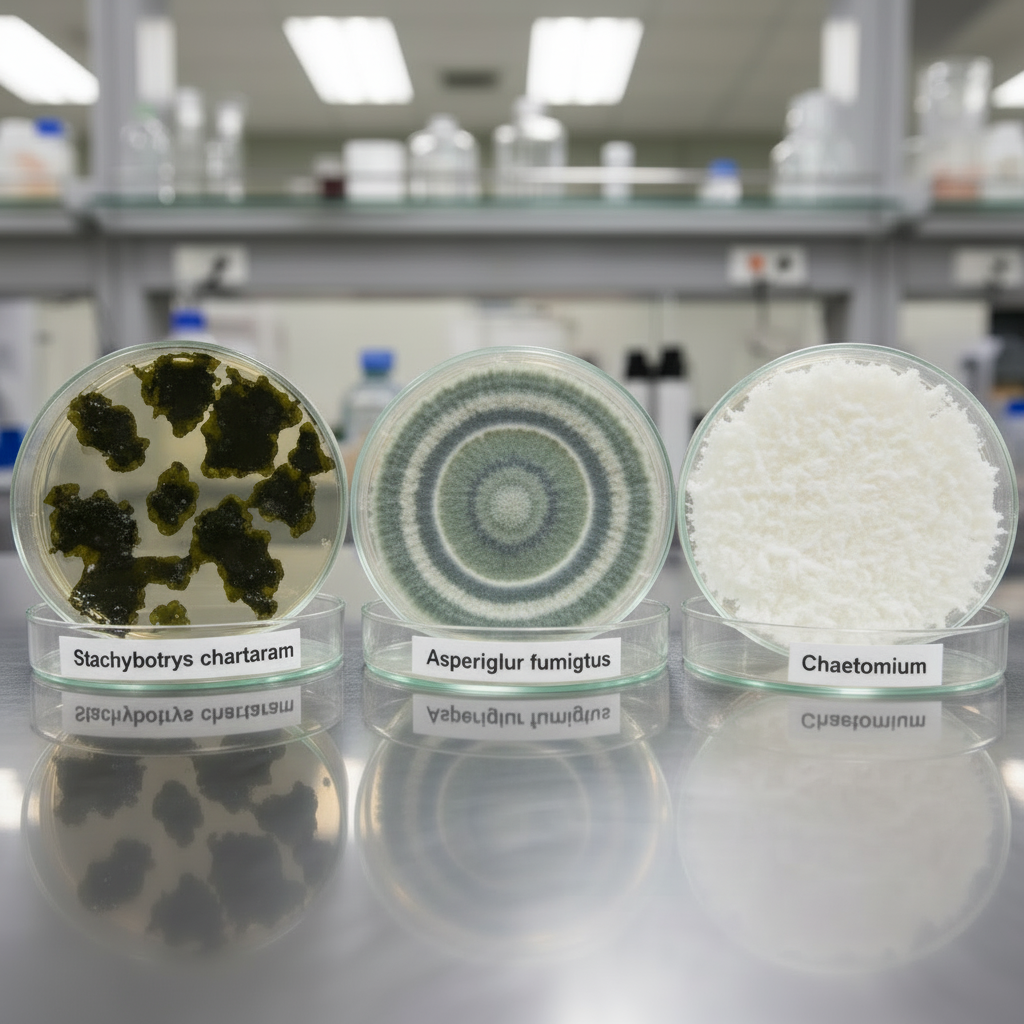
Illustration for What Makes Certain Mold Types Dangerous to Your Health? in 6 Toxic Mold Types That Threaten Your Family's Health

Identify 6 dangerous toxic mold types threatening your family. Expert guide covers black mold, health risks, professional testing & safe removal.
Key Takeaways
- # 6 Toxic Mold Types That Threaten Your Family's Health Toxic mold isn't just gross - it's dangerous
- Black mold, Aspergillus, and Chaetomium top our list of fungi that can trigger serious health problems
- ## What Makes Certain Mold Types Dangerous to Your Health
- Mycotoxins are the real culprit - toxic chemicals that certain mold species release into the air
Key Takeaways
6 Toxic Mold Types That Threaten Your Family's Health
Toxic mold isn't just gross - it's dangerous. We've inspected thousands of homes over the past 20 years, and here's what the pros know that DIY guides don't tell you: the worst offenders aren't always the obvious ones. Black mold, Aspergillus, and Chaetomium top our list of fungi that can trigger serious health problems.
What Makes Certain Mold Types Dangerous to Your Health?
Mycotoxins are the real culprit - toxic chemicals that certain mold species release into the air. During home inspections, our certified team identifies six particularly dangerous varieties: Stachybotrys chartarum (black mold), Aspergillus fumigatus, Chaetomium, Fusarium, Penicillium, and Trichoderma.
Not every fuzzy patch on your wall will kill you. But some can trigger asthma attacks, memory problems, and chronic fatigue. We've seen families suffer for months before discovering hidden mold colonies.
Sound familiar? Here's what's scary - these toxic varieties love the same spots regular mold does. Bathrooms. Basements. Areas with water damage. Once conditions are right, they can colonize your drywall within 24 hours of getting wet.
**Black Mold (Stachybotrys chartarum)** appears dark greenish-black with a slimy texture. It smells musty and earthy. We find it most often behind bathroom tiles and in flooded basements.
**Aspergillus fumigatus** shows up blue-green or yellow. It's powdery to the touch. In our experience, this one's particularly nasty for people with weak immune systems.
**Chaetomium** starts white but turns black over time. It looks like cotton balls. We've pulled this stuff from water-damaged insulation more times than we can count.
What's the most dangerous location for toxic mold? Your HVAC system. Once it gets in there, it spreads spores throughout your entire home.
How Can You Spot Dangerous Mold Without Professional Equipment?
Honestly, you can't identify toxic species without lab testing. But you can spot warning signs that scream "call a professional now."
Dark, slimy growth that won't scrub off easily? That's concerning. Multiple colors in one area? Even worse. Strong musty odors that don't go away? Red flag.
We inspected a home last month where the owner thought they had "just a small spot" in their closet. Lab results showed Stachybotrys chartarum. Turns out the contamination had spread behind three walls.
Look for these visual clues:
• Black or dark green growth with a wet, slimy appearance
• Blue-green patches that look powdery when dry
• White, cotton-like growth that darkens over time
• Pink or reddish growth on water-damaged wood
• Multiple colors growing in the same area
⚠️ Critical Mistake Most Homeowners Make
Don't grab that spray bottle! We've seen homeowners make this mistake countless times. Scrubbing or spraying suspected toxic mold releases a massive cloud of spores into your home's air.
Our licensed professionals follow strict containment protocols for good reason. If you find suspicious growth, seal off the area immediately. Use plastic sheeting and tape. Close nearby air vents. Only then should you call for professional testing.
What Professional Mold Inspectors Won't Tell You
Skip those $10 petri dish kits from the hardware store. They're basically worthless. Every home has mold spores floating around - these kits just confirm what we already know.
For real results, we recommend the MyMoldDetective air sampling kit. It uses an actual air pump (like our professional equipment) and provides lab analysis comparing indoor versus outdoor spore levels. You'll get actionable data instead of pointless panic.
What Health Problems Do Toxic Molds Actually Cause?
Initial symptoms from toxic mold exposure start small but get worse over time. According to the CDC, you'll likely notice persistent coughing, sneezing, and eye irritation first. But here's where it gets serious - prolonged exposure can trigger neurological problems.
We've documented cases where families experienced unexplained symptoms for months. Headaches that won't quit. Memory problems. Chronic fatigue. Kids developing asthma out of nowhere.
Who's most at risk? Children under 12, adults over 65, and anyone with compromised immune systems. We've seen previously healthy adults develop respiratory issues after just three months of exposure.
**Early Warning Signs:**
• Persistent cough that won't respond to medication
• Frequent sinus infections
• Unexplained headaches
• Difficulty concentrating
• Chronic fatigue
• New-onset asthma or allergies
**Severe Exposure Symptoms:**
• Memory loss
• Difficulty breathing
• Skin rashes
• Immune system suppression
• Nervous system problems
Research from the Environmental Protection Agency shows that mycotoxins can cause permanent health damage. Why does this matter? Because we don't mess around with suspected toxic mold.
Where Do Dangerous Mold Species Love to Hide?
Mold needs three things: moisture, food (organic material), and temperatures between 40-100°F. Basically, any normal indoor environment.
But toxic varieties have favorite spots. We find them most often in:
• Basements with humidity above 60%
• Bathrooms without proper exhaust fans
• Behind washing machines and water heaters
• Inside HVAC ducts
• Areas affected by roof leaks or plumbing problems
Here's what most people don't realize - your air conditioning system can spread toxic spores throughout your entire home. We've seen single-room contamination become whole-house problems because spores traveled through ductwork.
Maintain indoor humidity below 50% using commercial-grade dehumidifiers like the Aprilaire 1830. Anything higher creates perfect conditions for toxic mold growth.
Real Case: Family of Four Nearly Poisoned by Hidden Mold
Last spring, we inspected a 1,200 square foot ranch home. Four family members had been experiencing respiratory symptoms for six months. They'd seen multiple doctors. Nobody could figure out what was wrong.
Initial inspection revealed dark growth behind the kitchen sink. Basement ceiling tiles showed discoloration. That musty smell? It hit you the moment you walked in.
Lab analysis revealed a nightmare scenario: three toxic species in one home.
**Stachybotrys chartarum** - behind kitchen wall from a slow pipe leak
**Aspergillus niger** - throughout the HVAC ductwork
**Chaetomium globosum** - in basement insulation
All this contamination spread because of that tiny plumbing leak. Six months of undetected water damage created a toxic environment.
Remediation took five days and cost $8,500. But here's the important part - all four family members reported immediate symptom improvement after completion.
How Do Professionals Actually Test for Toxic Mold?

Accurate identification requires proper equipment and certified labs. Our pros use the Zefon Bio-Pump Plus for air sampling. We collect surface samples with sterile swabs. Bulk material testing analyzes contaminated building materials.
We follow EPA protocols for sample integrity. Chain of custody matters. Temperature control during transport matters. (Honestly? Most people don't realize these details determine whether your results are reliable.)
**Professional Testing Methods:**
1. **Air sampling** - Measures airborne spore concentrations
2. **Surface sampling** - Identifies species on visible growth
3. **Bulk sampling** - Analyzes contaminated materials
4. **Moisture mapping** - Locates hidden water sources
Reputable labs like EMSL Analytical and ALS Environmental perform species identification using direct microscopy and DNA analysis. Results include spore counts, species identification, and toxicity assessments.
What should lab results show? Indoor spore levels should match outdoor ambient conditions. Elevated indoor counts indicate contamination requiring professional remediation.
When Should You Call Certified Mold Professionals?
Call immediately if you discover growth larger than 10 square feet. Don't wait if family members experience unexplained health symptoms. Persistent musty odors mean contamination exists somewhere.
We hold IICRC certifications and follow strict containment protocols. We've seen too many DIY attempts spread contamination throughout homes.
Here's the truth - removing toxic mold safely requires specialized equipment. HEPA filtration. Negative air pressure. Proper disposal methods. Protective gear rated for mycotoxin exposure.
**Red Flags That Require Professional Help:**
• Growth covers more than 3 square feet
• Multiple family members show symptoms
• Previous water damage (flooding, leaks, high humidity)
• Musty odors that persist after cleaning
• Growth returns after cleaning attempts
How Can You Prevent Toxic Mold Before It Starts?
Prevention comes down to moisture control. Our 20+ years of experience proves this simple fact: no moisture means no mold.
Install bathroom exhaust fans rated for your room size. Standard is 1 CFM per square foot. Fix plumbing leaks the day you discover them. Maintain proper grading around your home's foundation.
**Proven Prevention Strategies:**
1. **Control humidity** - Keep levels below 50% year-round
2. **Fix leaks immediately** - Even small drips create problems
3. **Improve ventilation** - Fresh air prevents stagnant conditions
4. **Waterproof basements** - Ground moisture is a major culprit
5. **Regular HVAC maintenance** - Prevents duct condensation
Basement waterproofing systems and sump pumps like the Zoeller M53 control ground moisture effectively. Vapor barriers prevent moisture penetration into wall assemblies.
What Building Materials Actually Resist Mold?
Choose wisely during construction and renovation projects. Mold-resistant drywall like Georgia-Pacific DensArmor Plus costs slightly more but prevents major problems.
Closed-cell spray foam insulation doesn't support mold growth. Neither does moisture-resistant flooring like luxury vinyl plank or ceramic tile.
Proper vapor barrier installation following IRC Section R702.7 prevents moisture problems. We recommend 6-mil polyethylene sheeting for crawl spaces.
**Mold-Resistant Materials:**
• Mold-resistant drywall and paint
• Closed-cell spray foam insulation
• Metal and vinyl building materials
• Ceramic tile and luxury vinyl flooring
• Vapor barriers rated for your climate zone
Professional Removal: What Actually Works?

Professional remediation follows IICRC S520 standards. Teams wear N95 respirators minimum. Full protective suits are required. HEPA-filtered air scrubbers run continuously during work.
Small areas under 3 square feet might qualify for careful homeowner cleaning. Use 10% bleach solution on non-porous surfaces only. Anything larger requires professional intervention.
Why don't we recommend DIY removal for toxic species? Disturbing these colonies without proper containment releases massive amounts of spores and mycotoxins into your home's air.
**Professional Remediation Steps:**
1. **Containment setup** - Plastic barriers and negative air pressure
2. **Source elimination** - Fix water problems first
3. **Safe removal** - HEPA-filtered equipment and proper disposal
4. **Air scrubbing** - Remove airborne contamination
5. **Clearance testing** - Verify successful remediation
How Do You Know Remediation Actually Worked?
Successful projects include independent clearance testing. We don't test our own work - that's a conflict of interest.
Air sampling should show spore levels consistent with outdoor conditions. Visual inspection confirms complete removal of contaminated materials. Our detailed reports include before and after photography plus lab results.
Documentation like this proves essential for insurance claims and future property sales. Don't accept remediation without proper clearance testing.
**Questions to Ask Your Remediation Company:**
• Will an independent inspector perform clearance testing?
• What warranty do yo
In-Depth Look
Detailed illustration of key concepts

Visual Guide
Infographic illustration for this topic

Side-by-Side Comparison
Visual comparison of options and alternatives

Sources & References
- Black Mold vs. Other Mold Types: What to Know as a Homeowner
- A Brief Guide to Mold, Moisture and Your Home | US EPA
- Black Mold vs. Other Molds: What's the Difference?
- Black Mold vs Toxic Mold: 7 Critical Differences to Know
- Mold Inspection Guide: Spotting Mold vs. Black Mold in Your Home
- Building Codes, Standards, Regulations: FAQs
- Building Codes and Standards - 101 Guide
- Building Codes Toolkit for Homeowners and Occupants
- ICC - International Code Council - ICC
- Model Building Codes
Need Professional Help?
Find top-rated home services experts in your area
